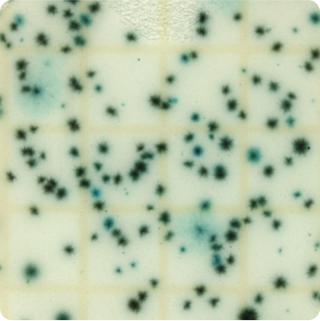

Total Yeast & Mold - Plate - 25g - Full Range
TYMFD
|
Turnaround Time:
3 - 5 days
|

Method Description
This comprehensive yeast and mold testing provides detection across all concentration ranges without predetermined limits, ensuring accurate results regardless of actual fungal contamination levels. This approach is valuable when contamination levels are unknown or when investigating spoilage incidents that may involve very high fungal counts. The full range testing provides maximum analytical flexibility for diverse sample types.
Analyte List
Technical Data Sheet
Method Name
Enumeration of Yeast and Mold in Foods and Dietary Supplements
Method Code
LAB-TM-061
Equipment Type
Culture Media - Plate
Equipment Details
3M Petrifilm (RYM)
Method Reference
USP <61> - Vendor Modified, USP <1223>, AOAC PTM 121301, AOAC OMA 2014.05
Reportable Unit
CFU/g, Swabs: CFU/Sw
Sample Size Requirements
100g
Available for
Food Products,
Dietary Supplements,
Botanicals (Raw Materials, Extracts, Finished Products),
API (Isolates, Active Ingredients),
Cannabis & Hemp (Plant Materials, Concentrates, MIP's),
Coffee
Additional Information
These are usually considered significant spoilage organisms in high acid or low water activity products. They can also serve as quality indicators in grain ingredients and products.
Both yeasts and molds cause various degrees of deterioration and decomposition of foods. They can invade and grow on virtually any type of food at any time; they invade crops such as grains, nuts, beans, and fruits in fields before harvesting and during storage. They also grow on processed foods and food mixtures. Their delectability in or on foods depends on food type, organisms involved, and degree of invasion. The contaminated food may be slightly blemished, severely blemished, or completely decomposed, with the actual growth manifested by rot spots of various sizes and colors, unsightly scabs, slime, white cottony mycelium, or highly-colored sporulating mold. (BAM Online 2001 Chapter 18 //www.cfsan.fda.gov/~ebam/bam-18.html)
Unavailable for
*Prices and offerings are subject to change without notice.